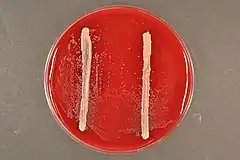
Description de cette image, également commentée ci-après

Tannerella forsythia
| Domaine | Bacteria |
|---|---|
| Embranchement | Bacteroidota |
| Classe | Bacteroidia |
| Ordre | Bacteroidales |
| Famille | Tannerellaceae |
| Genre | Tannerella |
Espèce
Tannerella forsythia, anciennement appelée Bacteroides forsythus, est l'espèce-type du genre de bactéries à Gram négatif Tannerella. Ces bactéries de la famille Tannerellaceae sont fréquemment isolées de patients atteints de maladies parodontales.
Historique
En , l'espèce Bacteroides forsythus qui était déjà considérée comme ne faisant probablement pas partie des Bacteroides est renommée Tannerella forsythensis car ses caractéristiques biochimiques particulières la différencie des genres les plus proches[2]. Les études phylogéniques ultérieures ont classé cette espèce et son genre dans une nouvelle famille nommée Tannerellaceae en compagnie des espèces du genre Parabacteroides[3].
Taxonomie
Étymologie
L'étymologie de l'espèce Tannerella forsythia est la suivante : N.L. fem. adj. forsythia, qui appartient centre dentaire Forsyth où elle a été isolée[2],[4].
Classification Phylogénique
L'analyse phylogénétique de l'ARNr 16S de la bactérie Bacteroides forsythus a présenté une similarité de séquence avec les espèces Bacteroides distasonis et Bacteroides merdae (88% et 91%, respectivement) qui sont les espèces les plus proches en phylogénie à ce moment-là mais suffisamment éloignée pour en faire une espèce et un genre distinct[2]. Une autre analyse phylogénique a positionné trois espèces de Parabacteroides proche de Tannerella et plus proche de Porphyromonas que des Bacteroides[5] ce qui a conduit le Bergey's Manual à classer ce groupe de bactéries à partir de dans la famille Porphyromonadaceae[6]. En , les Parabacteroides et les Tannerella sont reclassées dans la famille des Tannerellaceae nouvellement créée et incluses dans l'ordre des Bacteroidales[7], la classe des Bacteroidia et dans le phylum Bacteroidota[8]. Ce déplacement des deux genres bactériens et le nouveau nom de famille a été validé en par l'International Committee on Systematics of Prokaryotes[9].
Description
L'espèce Tannerella forsythia est une espèce de bactéries à Gram négatif, anaérobies strictes non mobiles et fusiformes[2].
Notes et références
- ↑ Sakamoto et et al. 2002, p. 841.
- 1 2 3 4 Sakamoto et et al. 2002, p. 848.
- ↑ Ormerod et et al. 2016, p. 12.
- ↑ (en) « Species Tannerella forsythia », sur LPSN,
- ↑ Sakamoto et Benno 2006, p. 1601.
- ↑ Krieg 2010, p. 61.
- ↑ Ormerod et et al. 2016, p. 36.
- ↑ (en) « Family Tannerellaceae », sur LPSN,
- ↑ (en) A Oren et George M. Garrity, « Validation list no. 206. List of new names and new combinations previously effectively, but not validly, published. », Int J Syst Evol Microbiol, vol. 72, , p. 5422 (DOI 10.1099/ijsem.0.005422)
Bibliographie
- (en) Mitsuo Sakamoto, Masahito Suzuki, Makoto Umeda, Isao Ishikawa et Yoshimi Benno, « Reclassification of Bacteroides forsythus (Tanner et al. 1986) as Tannerella forsythensis corrig., gen. nov., comb. nov. », Int J Syst Evol Microbiol, vol. 52, , p. 841-849 (DOI 10.1099/00207713-52-3-841)
- (en) Mitsuo Sakamoto et Yoshimi Benno, « Reclassification of Bacteroides distasonis, Bacteroides goldsteinii and Bacteroides merdae as Parabacteroides distasonis gen. nov., comb. nov., Parabacteroides goldsteinii comb. nov. and Parabacteroides merdae comb. nov. », International Journal of Systematic and Evolutionary Microbiology, vol. 56, no 7, , p. 1599-1605 (DOI 10.1099/ijs.0.64192-0)
- (en) Noel R. Krieg, « Family IV. Porphyromonadaceae fam. nov. », dans Krieg NR, Staley JT, Brown DR, Hedlund BP, Paster BJ, Ward NL, Ludwig W, Whitman WB (eds), Bergey's Manual of Systematic Bacteriology, vol. 4, New York, Springer, , 2nd edn éd. (DOI 10.1007/978-0-387-68572-4), p. 61
- (en) KL Ormerod, DL Wood, N Lachner, SL Gellatly, JN Daly, JD Parsons, CG Dal'Molin, RW Palfreyman, LK Nielsen, MA Cooper, Mark Morrison, Philip M. Hansbro et Philip Hugenholtz, « Genomic characterization of the uncultured Bacteroidales family S24-7 inhabiting the guts of homeothermic animals », Microbiome, vol. 4, , p. 36 (DOI 10.1186/s40168-016-0181-2)
Liens externes
- Ressources relatives au vivant :
- Ressource relative à la santé :
- Portail de la microbiologie